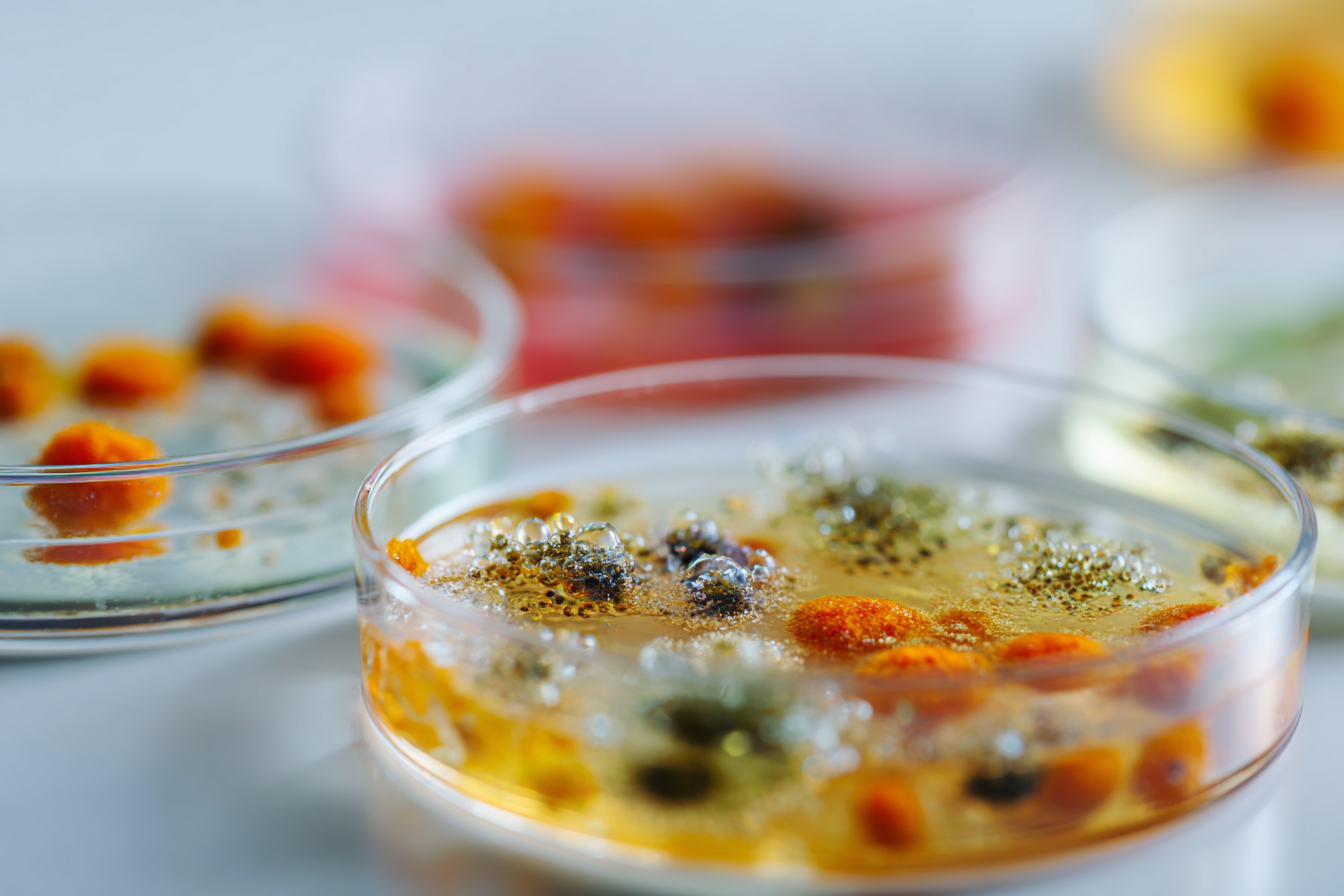

What are mycotoxins?
Here is a guide to some of the most common mycotoxins found in foods. For a deeper dive into the science of mycotoxins that can contaminate our food, visit our resources section, where new information will be posted monthly.
The increasing threat of mycotoxin contamination in processed foods sheds light on why eating fresh, locally grown foods is essential to maintaining good health. These foods are also packed with vital nutrients and antioxidants that protect your body by helping it to filter out toxins. The following are some suggestions for improving your health and limiting dietary mycotoxin exposures.
Limit or eliminate your intake of processed and ultra-processed foods. Foods with many ingredients often go through multiple processing and packaging steps, increasing the risk of harmful mold and mycotoxin contamination. Be your own food processor by preparing meals from fresh farm ingredients and freezing leftovers. This reduces exposure to mold and other toxic exposures from additives, preservatives, plastics, food colorings, and other processing chemicals.
Use filtered water for cooking and drinking. Many health-compromising toxins, including mycotoxins, can find their way into drinking water.
Gluten-containing grains often contain mycotoxins like DON, causing gastrointestinal issues. Fusarium infections have spread, leading to contamination in gluten-free grains like corn, oats, and rice. Consider removing grains such as wheat, corn, barley, oats, rye, sorghum, triticale, and rice, including cereals and pasta, for several weeks. Reintroduce less contaminated options like white rice, which loses some mycotoxins during processing but also loses prebiotic fiber.
If you are missing grain-based foods, non-grain flours like tapioca, arrowroot, coconut, and almond flour may be less contaminated, particularly with fewer gut-disrupting trichothecene mycotoxins, when good manufacturing processes are used, and can be used to make bread and similar foods.
Choose in-season, local fruits and vegetables for freshness. Select blemish-free produce, avoiding discolored ones with soft spots. Opt for fresh or frozen options over dried varieties, which are prone to mold. Berries like blueberries, blackberries, and raspberries boost phytochemicals and prebiotic fiber, helping prevent mycotoxin exposure. When possible, select organic produce for probiotic and prebiotic benefits. Incorporate cruciferous and leafy greens rich in toxin-eliminating compounds. Instead of commercial juices, make your own from fresh fruits and vegetables.
Fresh, organic carrots, potatoes, sweet potatoes, and turnips provide energy and nutrients for a healthy lifestyle. They are rich in antioxidants and polyphenols that may protect against mycotoxin exposure, but are also prone to mold-related diseases. Green-tinged skin, like on some potatoes, may indicate the presence of aflatoxin. Dark spots may indicate a Fusarium infection, which produces trichothecene mycotoxins such as DON. Always select fresh, healthy-looking produce.
Buy whole fresh nuts, not pieces, as they are less prone to mycotoxin contamination. Avoid discolored nuts. Choose trusted brands of commercial nut butters that monitor for mycotoxins, or make your own with fresh, cleaned nuts.
Even pasture-fed animal milk can contain mycotoxins from silage, hay, and moldy cheese, which harbor toxins. Consider limiting dairy and cheese for a few weeks, and when reintroducing, make homemade yogurt with probiotic cultures to reduce mycotoxin effects like Aflatoxin M1 and Zearalenone. Non-dairy milks like oat milk are also at risk for contamination. More testing and awareness for public safety.
Eat pasture-raised meat, fowl, and wild-caught fish whenever possible. Pasture-raised meats may contain fewer toxins. Avoid processed meats completely, as even the spices used during processing can be moldy.
Use fresh spices and herbs instead of dried ones whenever possible. Dried herbs and spices can be contaminated with multiple mycotoxins. Cinnamon, oregano, garlic, turmeric, and a few other dried spices have some antifungal properties and may be okay to use instead of fresh. Once a container of dried herbs or spices is opened, store it in a dehumidified refrigerator or freezer to keep it fresh.
Avoid pro-inflammatory seed oils like canola, corn, and soybean because they can contain mycotoxins and other toxins. Instead, choose anti-inflammatory oils high in monounsaturated fats and polyphenols, such as extra virgin olive oil and extra virgin avocado oil, for cooking and baking.
Tea and coffee are both moldy crops. Stick to brands that test for mycotoxins and take steps to prevent their occurrence, like Purity Coffee. Cocoa can be contaminated with ochratoxin A and aflatoxin. Addictive Wellness Chocolate tests their cacao powder for mycotoxins.
There is no way to prevent mycotoxin exposure from alcoholic beverages, and the distillation process does not completely remove them. Grain-based drinks are susceptible to contamination with DON, zearalenone, and ochratoxin A, among others. Some wine companies test for other contaminants, but to our knowledge, none test for mycotoxins.
Sweeteners
Replace refined commercial sugars that support fungal growth with honey or pure maple syrup. Honey and pure maple syrup serve as excellent sweeteners for cooking and baking. Both can help improve your microbiome and gut health and possess healing properties.
The Power of the Microbiome
Mycotoxins are external threats that may be mitigated by maintaining a healthy microbiome, which is populated by trillions of beneficial microbes. Including fermented foods such as sauerkraut, kimchi, or coconut/almond milk yogurt in your daily diet and taking a high-quality probiotic can help foster a healthier gut.